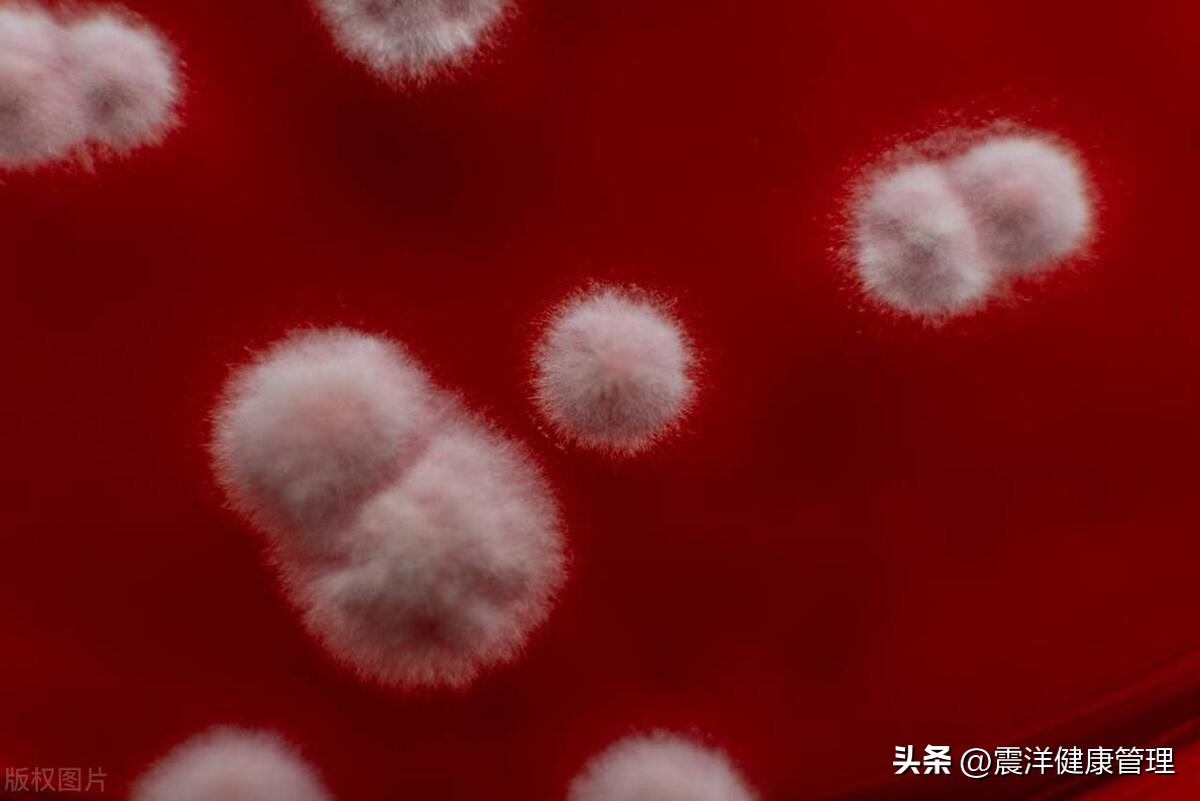
我30岁，注重卫生，但裆部异味重，差点把情人熏晕，这是咋回事？

患者提问:我是一个30岁的男人,工作繁忙,经常需要出差。由于工作性质的原因,我经常需要独自一人在外,而且和我的妻子许久见不到面,很多生理需求只能自己找办法解决。但是,最近我发现我的裆部异味越来越重,有一次和情人在一起时,她差点快被我的异味熏晕了。
我很注重个人卫生,每天都勤洗屁股和*裤内**,可是裆部的异味还是无法避免。这让我感到十分困扰,不仅影响了自己的生活品质,也影响了和情人的关系。请问这是什么情况呢?

医生回答:衣物清洗不彻底可能是其中一个原因。有些衣物可能需要使用专业的洗衣剂和消毒剂,以保证衣物内外的卫生。此外,也需要注意洗衣机内部的卫生情况,及时清洗滚筒和过滤器,避免洗涤剂残留和霉菌滋生,从而影响衣物的清洁度。
裤裆部位很容易滋生细菌和霉菌,这也是裆部异味的主要原因之一。尤其是夏天,人体排汗增多,容易滋生细菌和霉菌,从而导致异味问题。因此,除了勤洗屁股、*裤内**外,还需要注意裆部的干燥和通风,避免细菌和霉菌滋生。

个人生活习惯也可能影响裆部的异味。如饮食、穿着等。饮食过于油腻或刺激性食物,如辣椒、葱姜蒜等,会导致身体内部的气味增多,从而引起裆部异味。穿着过紧或材质不透气的衣物,容易导致裆部潮湿,从而加重异味问题。
裆部异味还可能与外部环境有关。如工作环境、生活环境等。如果工作环境潮湿或空气质量不佳,容易滋生细菌和霉菌,从而导致异味问题。同样,生活环境也需要注意通风和卫生情况,避免异味滋生。
最后,有些人可能存在一些身体问题,如泌尿系统感染、代谢紊乱等,也可能导致裆部异味。如果勤洗屁股、*裤内**等措施无效,建议及时就医,寻求医生的帮助。

裆部异味该如何正确处理?
裆部异味是一种比较常见的个人卫生问题,给人带来困扰和不适。为了处理裆部异味,我们可以从以下几个方面入手:
勤洗*裤内**。*裤内**是直接贴身的衣物,长时间穿戴容易累积污垢和细菌。因此,建议每天更换一次干净的*裤内**,同时使用专业的洗衣剂和消毒剂,保证*裤内**的清洁度。
勤洗屁股。每天洗澡时,要特别注意清洗屁股和裆部。可以使用专门的清洁剂或者肥皂来清洗,同时注意用水冲洗干净,避免残留。
注意裆部干燥和通风。裆部的潮湿容易滋生细菌和霉菌,从而导致异味问题。因此,需要注意裆部的干燥和通风,尤其是夏天多换衣服,避免衣物和皮肤潮湿。
饮食要健康。饮食过于油腻或刺激性食物,如辣椒、葱姜蒜等,会导致身体内部的气味增多,从而引起裆部异味。因此,要注意饮食健康,少吃油腻和刺激性食物。
注意穿着。穿着过紧或材质不透气的衣物,容易导致裆部潮湿,从而加重异味问题。建议选择透气性好的衣物,尽量避免过紧的衣物。
注意外部环境。工作环境、生活环境等也会影响裆部异味。如果工作环境潮湿或空气质量不佳,容易滋生细菌和霉菌,从而导致异味问题。同样,生活环境也需要注意通风和卫生情况,避免异味滋生。

这种该怎么预防呢?
为了预防男性出现异味问题,可以从以下几个方面入手:
保持个人卫生。每天勤洗澡,注意清洗屁股和裆部,使用专门的清洁剂或者肥皂,用水冲洗干净,避免残留。此外,需要勤洗*裤内**和换洗衣物,保持衣物内外的清洁度。
注意饮食。要注意饮食健康,少吃油腻和刺激性食物,避免身体内部气味增多。
注意环境卫生。工作环境、生活环境等也会影响异味问题。如果工作环境潮湿或空气质量不佳,容易滋生细菌和霉菌,从而导致异味问题。同样,生活环境也需要注意通风和卫生情况,避免异味滋生。

使用专业的洗涤剂和消毒剂。使用专业的洗涤剂和消毒剂,可以保证衣物内外的清洁度,避免滋生细菌和霉菌。
维持身体健康。定期进行身体检查,及时治疗身体问题,避免出现泌尿系统感染、代谢紊乱等问题,从而减少异味问题的发生。